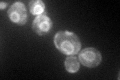
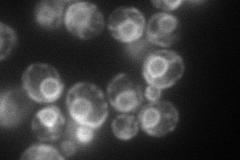
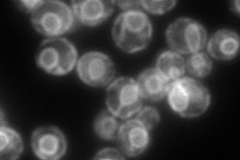
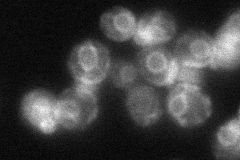
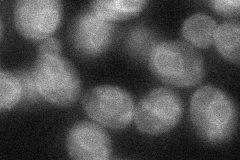

View description
Putative cytochrome b5 reductase, localized to the plasma membrane; may be involved in regulation of lifespan; required for maturation of Gas1p and Pho8p, proposed to be involved in protein trafficking
Localization:
Intensity:
Fold change:
Significance:
-
C’ GFP library in SD
ER74.63 -
N' NOP1pr-GFP in SD
ER112.338 -
N' TEF2pr-mCherry in SD
ER226.626 -
N' NATIVEpr-GFP in SD
ER49.0774 -
N' TEF2pr-VC and Cyto-VN in SD
ER43.5195 -
C’ GFP library in SD+DTT

ER53.30.71No -
C’ GFP library in SD+H2O2

ER57.130.76No -
C’ GFP library in Starvation Media

ER37.860.5Yes -
C’ GFP library on the background of Pup2-DaMP

N/A -
C’ GFP library on the background of CCT mutant

N/A0N/AYes
